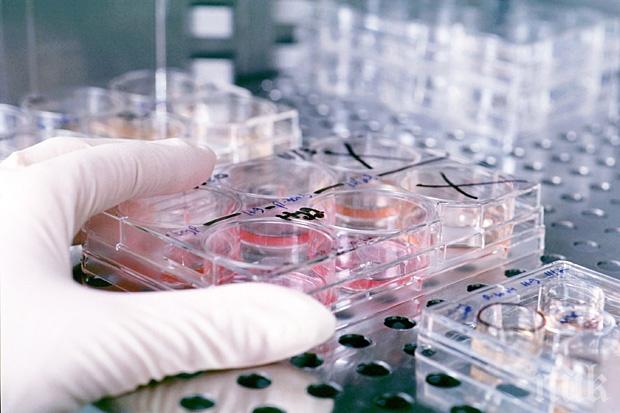
Японски учени за първи път успяха да отгледат ракови стволови клетки

ГОРЕЩО
Нов сценарий за КРАЯ НА СВЕТА: Учени взривяват досегашните теории за огнения апокалипсис
ГОРЕЩА ТЕМА! Топ експерт посочи всички СИЛНИ и СЛАБИ страни на бюджета на правителството (СНИМКА)
Евгений Михайлов гневно: Само ДПС ли доби смелост да се противопостави на идеята за закриването на Комисията по досиетата?
СКАНДАЛНО: Потъващата БСП се лепна за Йотова в битката за „Дондуков“ 2
Журналист с призив към ГЕРБ, ПП, ДБ и "Синя България": Последвайте позицията на ДПС за Комисията за досиетата! Времето е разделно
ПИК с нов канал в Телеграм
Последвайте ни в Google News Showcase
Японски учени успяха за първи път учени да отгледат ракови стволови клетки, съобщава РИА Новости. С помощта на технологията за създаване на изкуствени стволови клетки учените са успели да отгледат активни ракови клетки от раковите клетки на дебелото черво.
препоръчано
Учените смятат, че раковите стволови клетки са отговорни за бързата регенерация и растежа на злокачествените тумори. Възможността за тяхното производство по изкуствен начин представлява възможност за изучаването им и намирането на ефективни лекарства за лечение.

СЛЕД РЕКОРДА: Жената на Меси му се обясни в любов
35053
на 23.06.2026

ПОРЕДНИЯТ: Над 20 жени сочат с пръст популярен актьор и певец за сексуален тормоз
110735
на 11.06.2026

НЯМА КРАЙ: Нова мощна магнитна буря удря Земята
47626
на 09.06.2026

Стоичков с огромна изненада за своята 60-годишнина
51138
на 08.06.2026